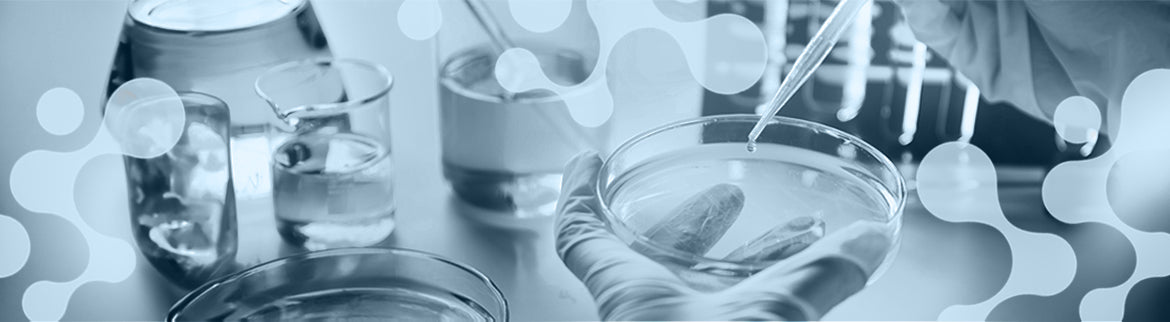

BMEM Bio was founded by the authors of the Stem Cell Reports paper:
"The Nutritional Requirements of Human Induced Pluripotent Stem Cells"
This publication described the invention of BMEM, a highly optimized for basal medium for hiPSC culture. The team shows that BMEM has numerous other applications in hiPSC research, including the ground-breaking protein-free cardiomyocyte differentiation kit.
The BMEM Bio team has developed pluripotent stem cell culture media and matrices specifically designed to be chemically defined with no animal-derived ingredients and to have the minimal components necessary. BMEM Bio products are highly optimized by in-house scientists, ensuring success in your hands the first time. BMEM Bio intentionally develops products and protocols to be robust with ease of use in mind. BMEM Bio is dedicated to cost-effective products, allowing you to complete larger scale experiments with more replicates and ultimately, better results. Finally, a unique quality of BMEM is the proprietary development method allowing for room temperature, environmentally-friendly shipping.